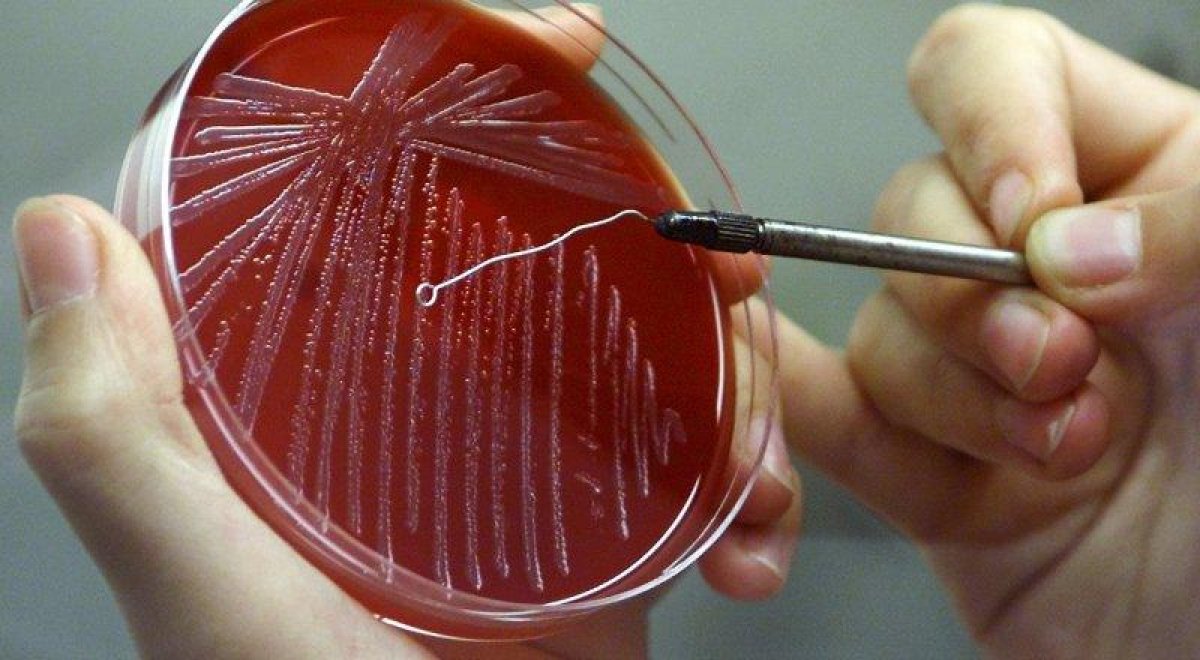

В селе Костанайской области ввели карантин из-за сибирской язвы
Три человека попали в больницу.
13.07.2021, 09:08
В Костанайской области в селе Приречное ввели карантин из-за вспышки сибирской язвы среди крупного рогатого скота. Зараженными оказались три человека, передает Liter.kz.
В акимате региона отметили, что карантин ввели еще 3 июля. Выяснилось, что первым заболевшим был пастух, на руках у которого были раны. Врачи сразу же его госпитализировали в инфекционную больницу с подозрением на сибирскую язву.
"Установлены были контактные лица. Всего в медицинское учреждение поступили три человека, которые находились под наблюдением и получали лечение", - рассказали в акимате Свердловского сельского округа Денисовского района.
На сегодня в селе проводятся вакцинация, дезинфекционные и ликвидационные работы. Карантин снимут по истечении 15-ти рабочих дней.


